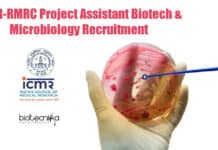
ICMR-RMRC Project Assistant Biotech & Microbiology Recruitment RMRC Project Jobs

South Asian University Tumor Overexpression Project Recruitment
SAU JRF Job - Cell Biology & Molecular Biology Apply
SAU JRF Job - Cell Biology & Molecular Biology Apply. South Asian University Junior Research...
ICMR-RMRC Project Assistant Biotech & Microbiology Recruitment
RMRC Project Jobs - Biotech & Microbiology ICMR Vacancy
RMRC Project Jobs - Biotech & Microbiology ICMR Vacancy. ICMR-RMRC is recruiting Graduate Degree in Biotechnology/...
National Institute of Immunology Fellow Recruitment – Applications Invited
SRF Job at NII - Applications Invited From MSc
SRF Job at NII - Applications Invited From MSc. Recruitment of MSc biochemistry, cell biology and...
Altem Technologies Life Science Division Inside Sales Recruitment
Altem Technologies Life Science Division Inside Sales Recruitment
Altem Technologies (P) Ltd is a leading Product Lifecycle Management (PLM) Software Partner for Dassault Systèmes and...
Is Self-medication Linked To Black Fungus Risk? – Voice of Biotecnika
Black Fungus & Self-medication Connection - Voice of Biotecnika
Voice of Biotecnika Podcast
Is Self-medication linked to Black fungus risk?
Hello Everyone
Welcome to another exciting episode of...
NIMR Life Sciences Jobs With Rs. 47,000 pm Salary, Attend Interview
NIMR Research Jobs - Life Science Eligible, Rs. 47,000 pm Pay
NIMR Research Jobs - Life Science Eligible, Rs. 47,000 pm Pay. ICMR-NIMR Life Sciences...
IACS PhD Life Sciences Research Associate Job Opening
IACS PhD Life Sciences Research Associate Job Opening
IACS PhD Life Sciences Research Associate Job Opening. PhD Life Sciences candidates are encouraged to apply for...
NIPGR Research Fellow Jobs For Life Science/ Biotech/ Biochem & Microbiology
NIPGR SRF Vacancy For Life Science/ Biotech/ Biochem
NIPGR SRF Vacancy For Life Science/ Biotech/ Biochem. MSc Life Sciences/ Biochemistry/ Biotechnology/ Microbiology Jobs. NIPGR RA...
National Institute of Nutrition Food Technology Project JRF
Project Junior Research Fellow Job at National Institute of Nutrition
Project Junior Research Fellow Job at National Institute of Nutrition. MSc Food Technology candidates are...
Wellcome Trust / DBT India Alliance IIT Delhi Life Sciences JRF Recruitment
IIT Delhi JRF Job - Applications Invited From Life Sciences
IIT Delhi JRF Job - Applications Invited From Life Sciences. If you want more details...
NIPGR Admission to Ph.D. Programme for 2021-2022 – Apply Online
NIPGR PhD Admissions 2021-22, Applications Invited Online
NIPGR PhD Admissions 2021-22, Applications Invited Online. NIPGR - National Institute of Plant Genome Research is inviting eligible...
DBT/Welcome Trust India Alliance Project JRF Recruitment at PGIMER
PGIMER Immunology Jobs - Biotech / Biochem & Life Science JRF
PGIMER Immunology Jobs - Biotech / Biochem & Life Science JRF. Junior Research Fellow...
Biotecnika Times – Newsletter 20.07.2021 – Govt ILS & Govt ICFRE-IWST Recruitment, BRICS
Biotecnika Times - Govt ILS & Govt ICFRE-IWST Recruitment, BRICS
CSIR-IICT Project Recruitment With Rs. 54,000 pm Salary – Applications Invited
IICT Jobs – Research Fellow...
UGC Cancels CUCET – Central Universities Common Entrance Test 2021-22
No common entrance test for central universities this year: UGC
The University Grants Commission (UGC) on 18 July 2021 stated that due to the current...
ACTREC Life Science / Biotech / Bioinformatics Research Job Openings
ACTREC Fellow Jobs - JRF & Trial Coordinator Vacancies
ACTREC Fellow Jobs - JRF & Trial Coordinator Vacancies. MSc candidates with relevant experience are encouraged...